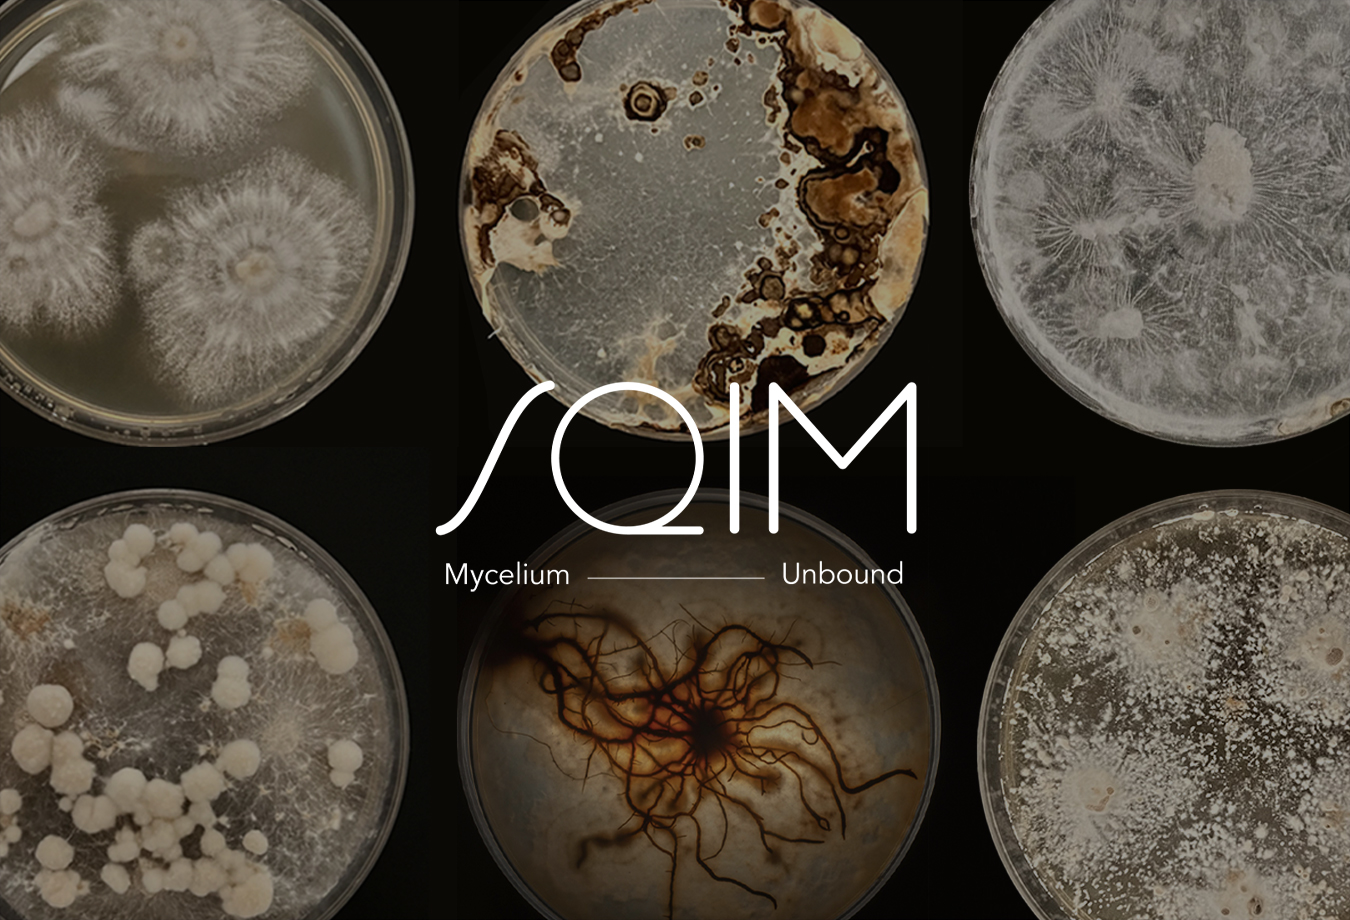
Sqim secures € 11 M for industrialization of mycelium technology

Category: Startup
-

Honeywell Completes Spin-Off of Solstice Advanced Materials
https://www.honeywell.com/us/en/press/2025/10/honeywell-completes-spin-off-of-solstice-advanced-materials
Written by
·
-

FutureBio startup to make completely recyclable plastic cost-competitive
https://www.dailycal.org/news/campus/research-and-ideas/futurebio-startup-to-make-completely-recyclable-plastic-cost-competitive/article_398f2b68-8a34-439d-a598-ad2166e4c363.html
Written by
·
-

Startup Dan*na begins industrial production of bioplastic
https://en.ara.cat/economy/startup-dan-na-begins-industrial-production-of-bioplastic_1_5513599.html
Written by
·
-

Sustainable packaging startup launches ‘first fully home-compostable pipette dropper’ for beauty packaging
https://www.cosmeticsdesign.com/Article/2025/09/26/sustainable-packaging-startup-launches-first-fully-home-compostable-pipette-dropper-for-beauty-packaging
Written by
·
-

Meet 4 chemistry start-ups navigating uncertainty in the Trump era
https://cen.acs.org/business/start-ups/Meet-4-chemistry-start-ups/103/web/2025/08
Written by
·
-

Corn Next Receives an Investment and Announces a L.A. Location (FREE)
ADVERTISING – New revolutionary biodegradable plastic resin from Symphony Environmental called ‘NbR’: Less fossil and CO2 emissions — This is a FREE article
Written by
·
-

Texas start-up sells plastic-eating fungi diapers to tackle landfill waste (FREE)
Read Texas start-up sells plastic-eating fungi diapers to tackle landfill waste
Written by
·
-

Joe Swash explores plastic-free packaging innovation in new meal deal documentary (FREE)
Read Joe Swash explores plastic-free packaging innovation in new meal deal documentary
Written by
·
-

Start-up transforms tea waste into paper, packaging and furniture (FREE)
Read Start-up transforms tea waste into paper, packaging and furniture
Written by
·
-

Maine startup aims to fight plastic pollution with kelp (FREE)
Read On the Record: Maine startup aims to fight plastic pollution with kelp
Written by
·
-

Chinese start-up introduces souvenir bags made from plastic waste (FREE)
Read Chinese start-up introduces souvenir bags made from plastic waste
Written by
·
-

It’s in the bag: Biodegradable plastic idea takes top prize in student startup pitch competition (FREE)
Read It’s in the bag: Biodegradable plastic idea takes top prize in student startup pitch competition
Written by
·
-

The Best Bioplastic Company of 2024 (FREE)
Here’s the best bioplastic company of 2024. This is a FREE article
Written by
·
-

Metsä Group invests in startup FineCell
Metsä Group invests in startup FineCell that produces pulp-based materials for beauty, healthcare, and paint products
Written by
·